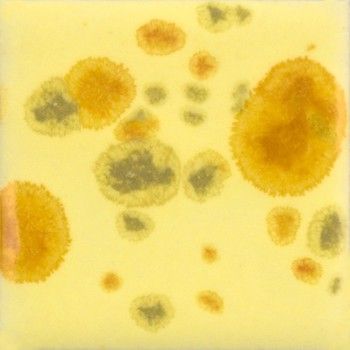
Mayco Haystack CG1012-118 ml

Webshop Clay-Obscuur
Actie tot en met 15 januari!
Gratis onderglazuurtransfer bij iedere bestelling boven €50
Mayco Haystack CG1012-118 ml
€10.30
Prijs incl. BTW (25.5%) €2.09
Op voorraad: 3 beschikbaar
1
Bewaar dit product voor later
Mayco Haystack CG1012-118 ml
Productgegevens
Vloeibare kant en klaar glazuur
Schudden of omroeren voor gebruik / 2 - 3 lagen aanbrengen
999°-1046°C / Hoger stoken kan, het effect is per kleur verschillend.
Onderling mengbaar.
Te gebruiken op leerharde of gebakken klei.
De Jungle gems zijn ook te combineren met andere glazuren van Mayco.
Kijk op de foto’s hier toegevoegd.
Van links naar rechts:
CG 1010 baktemperatuur 1040°C
CG 1010 baktemperatuur 1200°C
CG-1007 Blueberry Bubblegum
EL-212 Spotted Walnut
Toon prijzenEUR